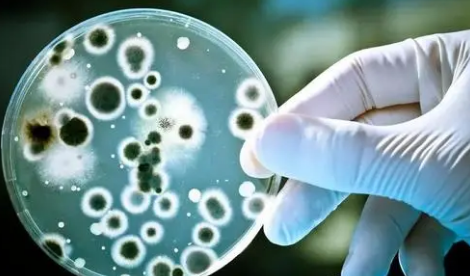
霉菌真菌念珠菌是一样的吗3

霉菌和念珠菌其实就是霉菌的俗称,也可以被称为真菌,虽说是同一种叫法,但两者还是有区别的,比如念珠菌是属于阴道炎的一种,表现正常是不一样的,治疗也需要一个周期,而霉菌主要是内源性传染,两者都要进行治疗。

霉菌、真菌和念珠菌都属于真菌门(Fungi),但它们是不同的类别和类型。霉菌是一种多细胞真菌,它们通常以菌丝形态存在,能够在许多不同的环境中生存和繁殖。真菌也是一种真菌,通常以单细胞形态存在,例如酵母菌。念珠菌也是真菌的一种,是一种通常以酵母菌形态存在的病原菌,它常常引起人类和动物的感染。虽然它们是不同类型的真菌,但它们都可以引起许多不同类型的疾病和感染,需要适当的治疗。

霉菌、念珠菌和真菌都是真菌的一种,但它们之间存在着一些区别。
形态:霉菌是多细胞真菌,通常以菌丝形态存在。念珠菌是单细胞真菌,通常以酵母菌形态存在。真菌既可以是多细胞真菌,也可以是单细胞真菌。
病原性:霉菌和念珠菌通常是人体内的病原菌,可以引起一系列疾病和感染,例如霉菌感染和念珠菌感染等。真菌也可以是病原菌,例如肺曲霉病等。
分布:霉菌和真菌广泛分布于土壤、植物和动物的身体表面,也可以在空气中存在。而念珠菌则主要分布于人体内的口腔、肠道、生殖系统等部位。
治疗:针对不同种类的真菌感染,需要使用不同的药物进行治疗,因为它们对不同的药物有不同的敏感性。例如,念珠菌感染通常使用抗真菌药物进行治疗,而霉菌感染则需要使用更强效的药物进行治疗。
虽然霉菌、念珠菌和真菌都属于真菌的范畴,但不同的真菌感染需要不同的治疗方法。一般来说,针对不同真菌感染的药物也不同。例如,一些针对念珠菌感染的药物可能对霉菌感染无效,反之亦然。如果有真菌感染的症状,建议尽快咨询医生并按医嘱使用适当的药物治疗。
相关热词:霉菌念珠菌真菌
茱萸对耳鸣眩晕有帮助吗
时间:2025-12-07
儿童吃茱萸有什么注意事项
时间:2025-12-07
孕妇可以服用茱萸吗
时间:2025-12-07
茱萸吃多了会出现哪些反应
时间:2025-12-07
银杏的主要健康功效有哪些
时间:2025-12-07
立冬如何做好皮肤护理
时间:2025-12-07
吃银杏真的能改善记忆力吗
时间:2025-12-07
银杏能促进血液循环吗
时间:2025-12-07
银杏对抗衰老有帮助吗
时间:2025-12-07
银杏对降血压有帮助吗
时间:2025-12-07